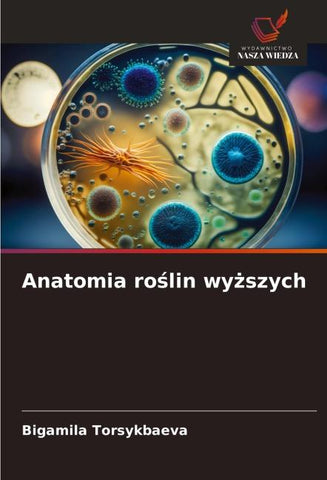
Anatomia ro¿lin wy¿szych

Autorenfreundlich Bücher kaufen?!

Beschreibung
Botanika jest dyscyplin¿ podstawow¿ dla specjalno¿ci farmaceutycznych i rolniczych. To g¿ównie determinowäo dobór materiäów do nauki i samodzielnego sprawdzania swojej wiedzy. Niniejszy podr¿cznik zwraca uwag¿ na cytologi¿, histologi¿, anatomi¿, morfologi¿ i fizjologi¿ ro¿lin. Sekcje te s¿ ¿ci¿le zwi¿zane z g¿ównymi dyscyplinami specjalno¿ci farmaceutycznych i rolniczych. Podr¿cznik przewiduje indywidualne podej¿cie do uczenia si¿, oparte na ró¿norodnych tre¿ciach i formach procesu edukacyjnego, który zapewnia rozwój kädego ucznia zgodnie z wielopoziomowymi zadaniami. Kädy ucze¿ ma swój w¿asny poziom zainteresowania i zdolno¿ci w tej dyscyplinie. Szkolenie pomaga kädemu zbudowä "sukces" w osi¿gni¿ciu mistrzostwa w botanice, przewidzie¿ wyniki, umiej¿tno¿ci i zdolno¿ci do zastosowania zdobytej wiedzy. Podej¿cie skoncentrowane na osobie zach¿ca do rozwoju, samodoskonalenia i przej¿cia na wy¿szy poziom zdobywania wiedzy. Jedn¿ z form szkolenia dla rozwoju aktywno¿ci poznawczej cäego procesu uczenia si¿ s¿ zadania wielopoziomowe.
Details
| Verlag | Wydawnictwo Nasza Wiedza |
| Ersterscheinung | 15. Januar 2025 |
| Maße | 22 cm x 15 cm x 1.5 cm |
| Gewicht | 375 Gramm |
| Format | Softcover |
| ISBN-13 | 9786208555030 |
| Seiten | 240 |
